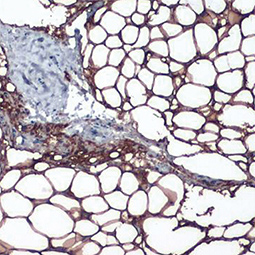
Perilipin 1 antibody Perilipin 1 antibody

肥胖症的特征是脂肪中的脂质累积增加,导致白色脂肪组织肥大、脂解作用受损以及其他组织中异位脂肪沉积。脂肪细胞也是高度活跃的分泌细胞,产生的蛋白质和激素的功能远超过新陈代谢。全世界的肥胖病流行已导致新陈代谢疾病的急剧增加,包括第二型糖尿病、慢性酒精中毒、非酒精性脂肪肝、脂肪性肝炎、哮喘、癌症、心血管疾病和神经退行性疾病,这些疾病与低度慢性炎症的产生有关。第二型糖尿病是由肥胖引起的白色脂肪组织、肝脏、骨骼肌的胰岛素抵抗,以及胰岛β细胞的胰岛素分泌异常所引起。了解促进肥胖相关疾病的分子机制,将加速针对这些经常造成破坏性疾病的新治疗方法的开发。
GeneTex为肥胖研究提供出色的精选抗体,包括脂肪生成、脂肪生物学和胰岛素抵抗信号传导等,这些抗体经过各种应用验证,以帮助您在这个令人兴奋的领域中努力,请查看下面热门研究产品。
| 热门研究产品 | |||||
|
|
|||||
|
|
|
|
|
|

![Fatty Acid Synthase antibody [N1], N-term Fatty Acid Synthase antibody [N1], N-term](/upload/media/research/metabolism/Obesity/GTX109833_1.jpg)
![Apolipoprotein E antibody [C2C3], C-term Apolipoprotein E antibody [C2C3], C-term](/upload/media/research/metabolism/Obesity/GTX100053_1.jpg)
![FABP4 antibody [N3C3] FABP4 antibody [N3C3]](/upload/media/research/metabolism/Obesity/GTX116036_1.jpg)